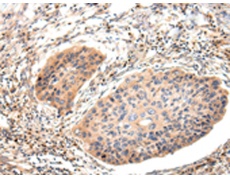
一抗

|
Background: |
Antibody producing cells of the immune system require multiple rearrangements of immunoglobulin (antibody, Ig) genes. Immunoglobulins are four-chain, Y-shaped, monomeric structures of two identical heavy chains and two identical light chains held together through interchain disulfide bonds. Immunoglobulins in vertebrates help to remove non-self molecules or cells (antigens) by recognizing and binding to the antigen and carrying out effector functions that activate the immune system. Variable genetic combinations of the five heavy chain classes (M, D, G, E and A) and the two light chain isotypes, Kappa and Lambda, confer the role of an antibody. The variable region genes encoding immunoglobulin Kappa and Lambda chains are assembled from three DNA segments, the V, C and J genes. Kappa and Lambda consist of a variable region and a constant region and can easily be differentiated by the antigenic properties of the constant region. The ratio of Kappa to Lambda is 70:30 , the vast majority of which is bound to heavy-chain in immunoglobulin. |
|
Applications: |
ELISA, WB, IHC |
|
Name of antibody: |
Lambda Light chain |
|
Immunogen: |
Synthetic peptide of human Lambda Light chain |
|
Full name: |
Ig lambda chain V-I region NEW |
|
Synonyms: |
λlight chain |
|
SwissProt: |
P01701 |
|
ELISA Recommended dilution: |
1000-2000 |
|
IHC positive control: |
Human esophagus cancer and Human thyroid cancer |
|
IHC Recommend dilution: |
25-100 |
|
WB Predicted band size: |
25 kDa |
|
WB Positive control: |
Human plasma solution |
|
WB Recommended dilution: |
200-1000 |


 購物車
購物車 幫助
幫助
 021-54845833/15800441009
021-54845833/15800441009